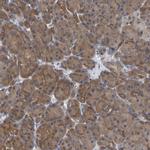
ALAD Antibody in Immunohistochemistry (IHC)

Search
Invitrogen
ALAD Polyclonal Antibody
{{$productOrderCtrl.translations['antibody.pdp.commerceCard.promotion.promotions']}}
{{$productOrderCtrl.translations['antibody.pdp.commerceCard.promotion.viewpromo']}}
{{$productOrderCtrl.translations['antibody.pdp.commerceCard.promotion.promocode']}}: {{promo.promoCode}} {{promo.promoTitle}} {{promo.promoDescription}}. {{$productOrderCtrl.translations['antibody.pdp.commerceCard.promotion.learnmore']}}
图: 1 / 8
ALAD Antibody (PA5-54310) in IHC (P)

产品信息
PA5-54310
种属反应
宿主/亚型
分类
类型
抗原
偶联物
形式
浓度
规格
纯化类型
保存液
内含物
保存条件
运输条件
RRID
产品详细信息
Immunogen sequence: GCQVVAPSDM MDGRVEAIKE ALMAHGLGNR VSVMSYSAKF ASCFYGPFRD AAKSSPAFGD RRCYQLPPGA RGLALRAVDR D
Highest antigen sequence identity to the following orthologs: Mouse - 94%, Rat - 94%.
靶标信息
The ALAD enzyme is composed of 8 identical subunits and catalyzes the condensation of 2 molecules of delta-aminolevulinate to form porphobilinogen (a precursor of heme, cytochromes and other hemoproteins). ALAD catalyzes the second step in the porphyrin and heme biosynthetic pathway; zinc is essential for enzymatic activity. ALAD enzymatic activity is inhibited by lead and a defect in the ALAD structural gene can cause increased sensitivity to lead poisoning and acute hepatic porphyria.The ALAD enzyme is composed of 8 identical subunits and catalyzes the condensation of 2 molecules of delta-aminolevulinate to form porphobilinogen (a precursor of heme, cytochromes and other hemoproteins). ALAD catalyzes the second step in the porphyrin and heme biosynthetic pathway; zinc is essential for enzymatic activity. ALAD enzymatic activity is inhibited by lead and a defect in the ALAD structural gene can cause increased sensitivity to lead poisoning and acute hepatic porphyria. Alternatively spliced transcript variants encoding different isoforms have been identified.
仅用于科研。不用于诊断过程。未经明确授权不得转售。
篇参考文献 (0)
生物信息学
蛋白别名: ALADH; aminolevulinate, delta-, dehydratase; delta-aminolevulinate dehydratase (EC 4.2.1.24); Delta-aminolevulinic acid dehydratase; Porphobilinogen synthase; testicular tissue protein Li 95; unnamed protein product
基因别名: ALAD; ALADH; PBGS
UniProt ID: (Human) P13716
Entrez Gene ID: (Human) 210




